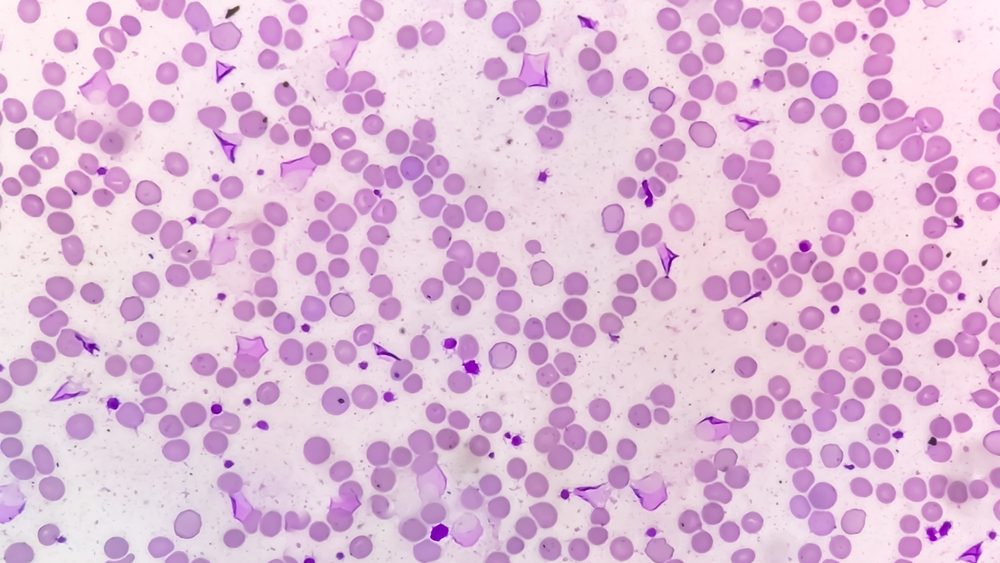
Revolucionarno otkriće: Nova terapija uništila vrstu raka koja je do sada bila neizlečiva

Naučnici otkrili protein odgovoran za smrtonosne misteriozne bolesti
Telegraf
1
Naučnici su otkrili da protein RPA igra ključnu i ranije nepotvrđenu ulogu u stimulisanju telomeraze radi očuvanja dugih, zdravih telomera.
Pročitajte ceo članak na originalnom izvoru
Pročitaj na Telegraf